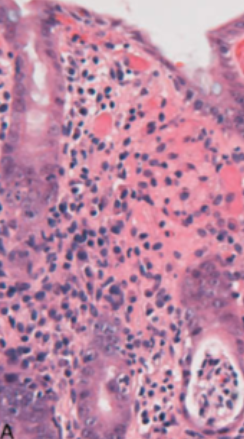

50yo male presents with burning, intermittent retrosternal pain that is partially relieved by antacids

Reflux oesophagitis

20yo male presents with difficulty swallowing food. It is worse when he eats certain foods and is not relieved by antacids. He has a history of asthma and eczema

Eosinophilic oesophagitis
45yo obese male presents with burning retrosternal pain after meals. It is worse when lying down or leaning forward
GORD
66yo patient presents with dysphagia to solids and liquids. This is aided by postural change. Associated history of mild, ongoing weight loss and regurgitation

Achalasia
60yo male with long-standing GORD and progressive dysphagia. Most likely pathology seen on endoscopy?

Barrett’s oesophagus

75yo male with heavy smoking and alcohol histories presents with progressive dysphagia and weight loss

Oesophageal cancer (SCC)

75yo obese male with long-standing GORD presents with progressive dysphagia and weight loss

Oesophageal cancer (adenocarcinoma)
55yo woman with chronic hepatitis C infection presents with haematemesis and melaena. She later becomes hypotensive and tachycardic

Oesophageal varices
60yo patient with burning epigastric pain, relieved by antacids. She has a history of arthritis for which she takes an NSAID daily

PUD
60yo patient with history of burning epigastric pain presents with acute onset sharp epigastric pain, that is worse on movement and is associated with melaena and haematemesis

Ruptured peptic ulcer
55yo male presents with persistent, vague epigastric pain for many months. Associated with this is nausea and weight loss. He has a history of H. pylori infection

Stomach cancer (adenocarcinoma shown)
22yo woman travelling in Thailand presents with 4 hours of vomiting and diarrhoea, associated with crampy abdominal pain
Infectious enterocolitis
65yo patient who has been in hospital and on broad spectrum antibiotics complains of new onset diarrhoea, abdominal pain and fever

Pseudomembranous colitis

33yo patient presents with diarrhoea associated with crampy abdominal pain localised to the RLQ. Associated with this is a fever and mild arthralgia

Crohn’s disease

45yo male presents with two months of faecal frequency with loose stools, urgency and tenesmus. Associated with this is abdominal pain prior to defaecating and rectal bleeding

Ulcerative colitis

22yo patient presents with a chronic history of diarrhoea, bloating, flatulence and abdominal cramps. The patient is HLA DQ2 positive

Coeliac disease
80yo male with CVD risk factors presents with sudden onset periumbilical pain and tenderness. This pain appears out of proportion to the perceived pain

Ischaemic bowel disease
Other causes: arterial compromise (embolus, thrombus, vasculitis, external compression), venous thrombosis, shock or hypotension

55yo patient presents with LLQ pain and fever. They describe a past history of bloating and constipation (with occasional intermittent diarrhoea)

Diverticulitis
A patient presents with crampy abdominal pain associated with bilious vomiting, abdominal distension and constipation. They have had previous abdominal surgery

SBO
Causes: adhesions from previous surgery, inguinal hernia with incarceration, Crohn’s disease, malignancy, appendicitis
A patient with known CRC presents with progressive distension associated with obstipation and faeculent vomitus

LBO
Causes: CRC, colonic volvulus, benign stricture
65yo male presents with a 6 month history of rectal bleeding and change in bowel habit. Associated with this he has a many month history of unintentional weight loss and fatigue

CRC

A 30yo female presents with a 3 month history of “erratic” bowel habits and bloating. This is made worse by stress and eating certain foods
IBS
A 55yo known IVDU presents with fatigue and increasing confusion. On examination, he is jaundiced, and spider naevi and ascites are noted
Chronic liver disease/cirrhosis Causes: viral hepatitis, alcoholic hepatitis, autoimmune hepatitis, inherited liver disease
A 45yo patient with CVD risk factors presents with deranged LFTs

Fatty liver disease